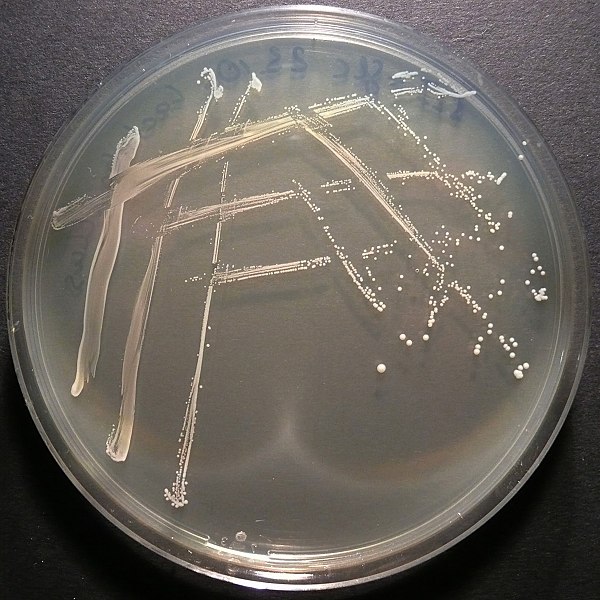

LEoPARD has presented its research in poster format at a national meeting, the 2024 Canadian Society for Chemistry annual meeting. This is an updated and revamped version of the work that was presented at the institutional meeting, the 2023 Saint Michael's College Academic Symposium. This is an exciting accomplishment, marking the first national meeting at … Continue reading LEoPARD presents its research on a national stage
Local Vermont youths introduced to principles of insulin resistance, drug discovery
On Saturday, December 10th, local Vermont youths were treated to a presentation and hands-on activities in which they were introduced to insulin resistance, drug discovery, and bioactive natural products in agricultural sources. Dr. Chris Dieni delivered a presentation entitled “Insulin Resistance: A Global Health Problem with a Backyard Solution?” Insulin resistance is a metabolic disorder … Continue reading Local Vermont youths introduced to principles of insulin resistance, drug discovery
LEoPARD awarded internal grant from Vermont Biomedical Research Network
LEoPARD has been awarded an internal grant at maximum value — a full request of $2,000 — by the Vermont Biomedical Research Network (VBRN). Funds received from the grant application — entitled “Quantitative structure-activity relationship (QSAR) study of commercially-available capsaicin, capsaicinoids, capsinoids, and their biosynthetic intermediates: enzymatic and cellular approaches” — is added to a previous … Continue reading LEoPARD awarded internal grant from Vermont Biomedical Research Network
LEoPARD to present at VTeen 4-H Science Pathways Café @ UVM
LEoPARD has been granted a phenomenal opportunity to engage in STEM outreach with young, future prospective scientists in the Burlington metro area. On December 10th, LEoPARD will deliver a presentation to interested and enthusiastic teens at the VTeen 4-H Science Pathways Cafés, organized and offered by the University of Vermont (UVM) Extension. The presentation is … Continue reading LEoPARD to present at VTeen 4-H Science Pathways Café @ UVM
LEoPARD awarded startup supplement funds from Vermont Biomedical Research Network
LEoPARD has been awarded a startup supplement grant at maximum value -- a full request of $10,000 -- by the Vermont Biomedical Research Network (VBRN). Funds received from the grant application -- entitled “Characterizing capsaicinoid and capsinoid mechanisms of insulin sensitization” -- will be added to a startup package already committed by Saint Michael's College. … Continue reading LEoPARD awarded startup supplement funds from Vermont Biomedical Research Network
LEoPARD comes home
After a very circuitous few years in Colorado and Alabama, the Laboratory for Evaluation of Pharmacological Agents in Remediation of Disease (LEoPARD) is effusively thrilled to announce its return to friendlier lands. LEoPARD has now joined the Department of Chemistry at Saint Michael's College, a private liberal arts college located in Colchester, Vermont -- within … Continue reading LEoPARD comes home
LEoPARD features in a CMUnow story
Recently, we were visited by Kelsey Coleman, Creative Content and Social Media Specialist at the Colorado Mesa University Marketing and Communications office. Visiting with student-researchers Brett Duncan and Austin Lorenz, she crafted a truly inspirational story. The story can be read at CMUnow -- the official hub for news and stories from Colorado Mesa University, … Continue reading LEoPARD features in a CMUnow story
The Centennial State
We've moved (yes, again)! It seems like we had only just arrived at the University of Windsor -- but, for context, it had actually been about a year-and-a-half (January 2018 through June 2019), and much was accomplished during that time. We won several internal research awards for supporting undergraduate research, such as an Undergraduate Research … Continue reading The Centennial State
Our mentee Callum Yoker wins big at Canada-Wide Science Fair
We at LEoPARD are effusively proud of our young mentee, Callum Yoker! Callum is a 13 year-old student at Tecumseh Vista Academy, who in late-March participated in the Windsor Regional Science, Technology, and Engineering Fair, and won the St-Clair College CWSF Grand Prize. By way of this award, he was selected to represent the Windsor … Continue reading Our mentee Callum Yoker wins big at Canada-Wide Science Fair
Undergraduate Research Incentive Fund (URIF) awarded
Happy holidays! We're thrilled to have been awarded a University of Windsor Faculty of Science Undergraduate Research Incentive Fund (URIF), which will help us with an undergraduate project already underway. We previously reported having been awarded an Undergraduate Research Experience (URE) grant, which is currently funding an undergraduate-driven research project, Development of a gut-friendly probiotic towards the … Continue reading Undergraduate Research Incentive Fund (URIF) awarded